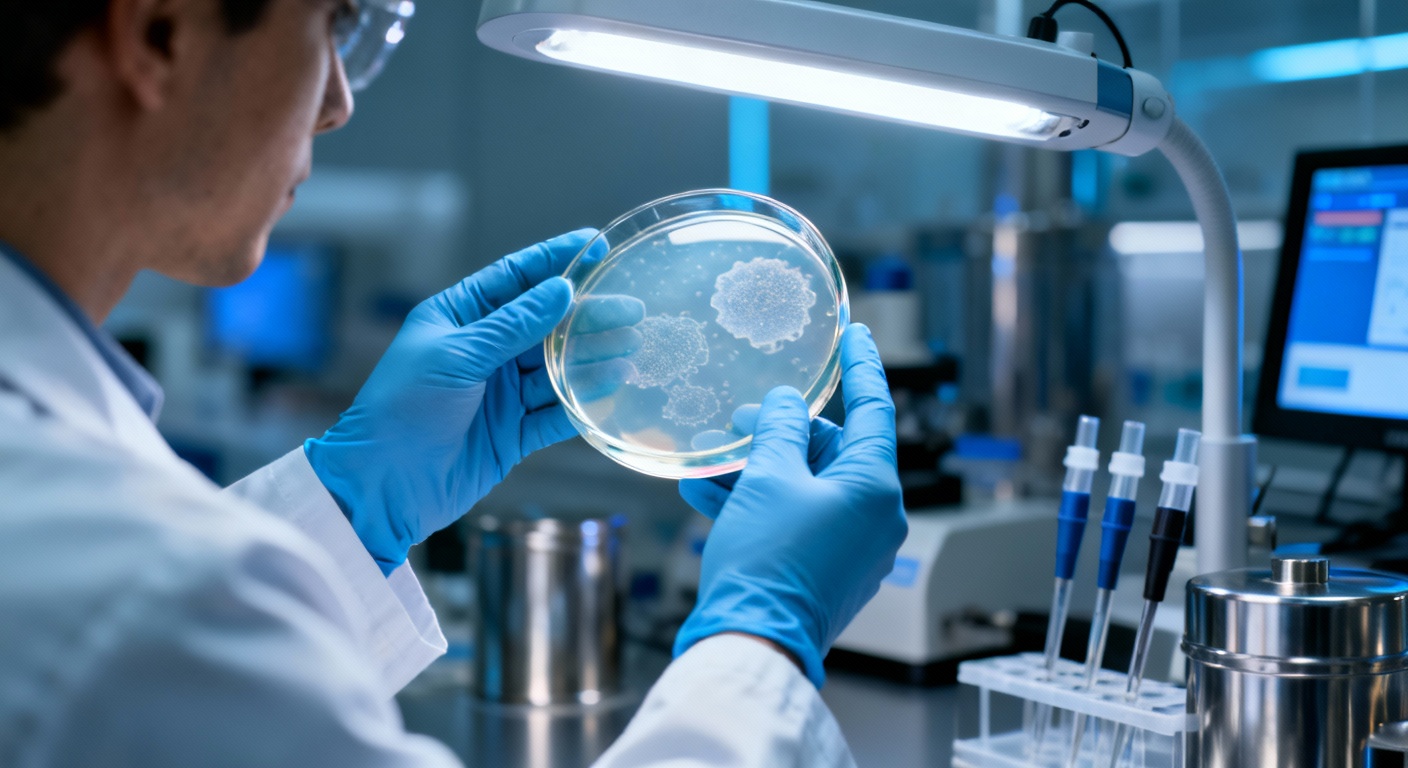
Cancer : Une nouvelle stratégie d&rsquo;immunothérapie fait sauter les verrous moléculaires

Cancer : Une nouvelle stratégie d’immunothérapie fait sauter les verrous moléculaires
Auteur: Mathieu Gagnon
Quand la science lève le pied du frein

C’est une de ces nouvelles qui redonne un peu d’espoir, vous ne trouvez pas ? En ce 19 décembre 2025, une équipe de chercheurs, et pas des moindres puisqu’ils viennent du MIT et de l’Université de Stanford, vient de dévoiler une approche assez fascinante pour traiter le cancer. L’idée est simple sur le papier, mais incroyablement complexe en réalité : ils ont trouvé un moyen de désactiver un « frein » biologique caché que les tumeurs utilisent sournoisement pour échapper à notre système immunitaire. C’est un peu comme si les cellules cancéreuses se déguisaient pour passer inaperçues, et que nos scientifiques venaient enfin de leur arracher ce masque.
Au cœur de cette découverte, on trouve des structures appelées AbLecs. Ce sont des molécules hybrides, conçues en laboratoire, qui viennent bloquer un point de contrôle immunitaire bien spécifique. L’étude, menée par Jessica Stark — qui occupe la chaire Underwood-Prescott de développement de carrière au sein des départements de génie biologique et chimique du MIT — suggère que cette méthode pourrait déclencher une réponse immunitaire puissante contre les tumeurs. Stark, également affiliée à l’Institut Koch pour la recherche intégrative sur le cancer au MIT, a travaillé main dans la main avec l’auteure principale, Carolyn Bertozzi. Bertozzi est professeure de chimie à Stanford et dirige l’Institut Sarafan ChEM. Leurs travaux ont été publiés très récemment, le 16 décembre 2025 pour être précis, dans la revue Nature Biotechnology sous le DOI 10.1038/s41587-025-02884-6. Je pense sincèrement que nous sommes à l’aube de quelque chose d’important pour les patients qui, jusqu’ici, ne répondaient pas aux traitements classiques.
Le sucre, ce bouclier invisible des tumeurs

Pour bien comprendre, il faut plonger un peu dans la mécanique de notre corps. Entraîner le système immunitaire à détruire les tumeurs, c’est ce qu’on appelle l’immunothérapie, et c’est une piste très prometteuse. Vous avez peut-être entendu parler des inhibiteurs de points de contrôle ? Ces médicaments, qui ciblent les protéines PD-1 et PD-L1, ont déjà été approuvés pour plusieurs cancers. Ils fonctionnent en levant un frein, permettant aux lymphocytes T de faire leur travail de nettoyage. Pour certains patients, c’est miraculeux, avec des rémissions durables. Mais… et c’est là le hic, pour beaucoup d’autres, ça ne marche tout simplement pas. C’est frustrant, n’est-ce pas ?
C’est ici que l’équipe de Stark et Bertozzi change la donne. Ils se sont intéressés à une autre interaction immunosuppressive, celle qui implique les glycanes. Ce sont des molécules de sucre présentes à la surface des cellules. Si les glycanes sont partout, les cellules tumorales, elles, en arborent certains types qu’on ne trouve pas sur les cellules saines, notamment ceux contenant un monosaccharide appelé acide sialique. C’est un peu technique, je vous l’accorde, mais suivez-moi : quand ces acides sialiques se lient à des récepteurs appelés lectines (ou Siglecs) sur les cellules immunitaires, ils activent une voie qui… eh bien, qui éteint la réponse immunitaire. Comme le dit Jessica Stark : « Lorsque les Siglecs des cellules immunitaires se lient aux acides sialiques des cellules cancéreuses, cela freine la réponse immunitaire. » C’est exactement le même principe que le PD-1, mais via un chemin différent.
Le problème, c’est qu’il n’existait aucun médicament approuvé ciblant cette interaction Siglec-acide sialique. Pourquoi ? Parce que les tentatives précédentes pour créer des lectines capables de bloquer ce processus ont échoué. Les lectines seules ne se liaient pas assez fort. C’est là que le génie intervient : pour contourner cet obstacle, Stark et ses collègues ont créé ces fameux AbLecs. Ils ont attaché des lectines à des anticorps qui ciblent spécifiquement les cellules cancéreuses. Une fois sur place, la lectine peut enfin se lier à l’acide sialique et empêcher ce dernier d’interagir avec les récepteurs Siglec des cellules immunitaires. Cela libère les freins, permettant aux macrophages et aux cellules tueuses naturelles (NK) de lancer l’assaut. C’est une astuce brillante, je trouve : utiliser un anticorps comme véhicule pour livrer la lectine exactement là où il faut.
Des résultats prometteurs et une technologie « Plug-and-Play »

Alors, est-ce que ça marche ? Les chercheurs ont conçu un AbLec basé sur l’anticorps trastuzumab. Si ce nom vous dit quelque chose, c’est normal : c’est un médicament approuvé ciblant HER2, utilisé pour traiter les cancers du sein, de l’estomac et les cancers colorectaux. Ils ont remplacé un bras de cet anticorps par une lectine, soit Siglec-7, soit Siglec-9. Les tests en laboratoire ont montré que cela reprogrammait littéralement les cellules immunitaires pour qu’elles détruisent le cancer. C’est assez incroyable.
Mais ils ne se sont pas arrêtés là. Ils ont testé leurs AbLecs sur des souris modifiées pour exprimer des récepteurs Siglec humains. Ces petites bêtes, malheureusement injectées avec des cellules cancéreuses formant des métastases aux poumons, ont montré des résultats frappants : celles traitées avec l’AbLec avaient beaucoup moins de métastases pulmonaires que celles traitées avec le trastuzumab seul. Ce qui est encore plus fascinant, c’est la modularité du système. Stark explique que les AbLecs sont vraiment « plug-and-play ». On peut changer l’anticorps : ils ont essayé avec le rituximab (qui cible CD20) ou le cetuximab (qui cible EGFR). On peut aussi changer la lectine ou même cibler d’autres protéines comme PD-1. « Vous pouvez imaginer échanger différents domaines de récepteurs leurres… c’est important car différents types de cancer expriment différents antigènes », précise Stark. Cette flexibilité ouvre des portes immenses.
Conclusion : Vers des essais cliniques et un nouvel espoir

Tout cela ne reste pas confiné aux murs du laboratoire. Jessica Stark, Carolyn Bertozzi et d’autres ont cofondé une entreprise, Valora Therapeutics, qui travaille d’arrache-pied pour développer ces candidats AbLec. Leur objectif ? Lancer des essais cliniques dans les deux ou trois prochaines années. C’est demain, ou presque ! Bien sûr, la route est encore longue, mais voir une application concrète se profiler aussi vite est rassurant.
Il ne faut pas oublier que cette recherche colossale a été rendue possible grâce à une multitude de financements. La liste est longue, mais il est important de saluer ces soutiens : le Burroughs Wellcome Fund Career Award, le prix Steven A. Rosenberg de la Society for Immunotherapy of Cancer, une subvention V Scholar de la V Foundation, sans oublier le National Cancer Institute et le National Institute of General Medical Sciences. Ajoutez à cela une subvention Merck Discovery Biologics SEEDS, une bourse postdoctorale de l’American Cancer Society et une subvention de démarrage Sarafan ChEM-H. C’est un bel exemple de ce que l’effort collectif et le financement de la science peuvent produire de meilleur.
Ce contenu a été créé avec l’aide de l’IA.










